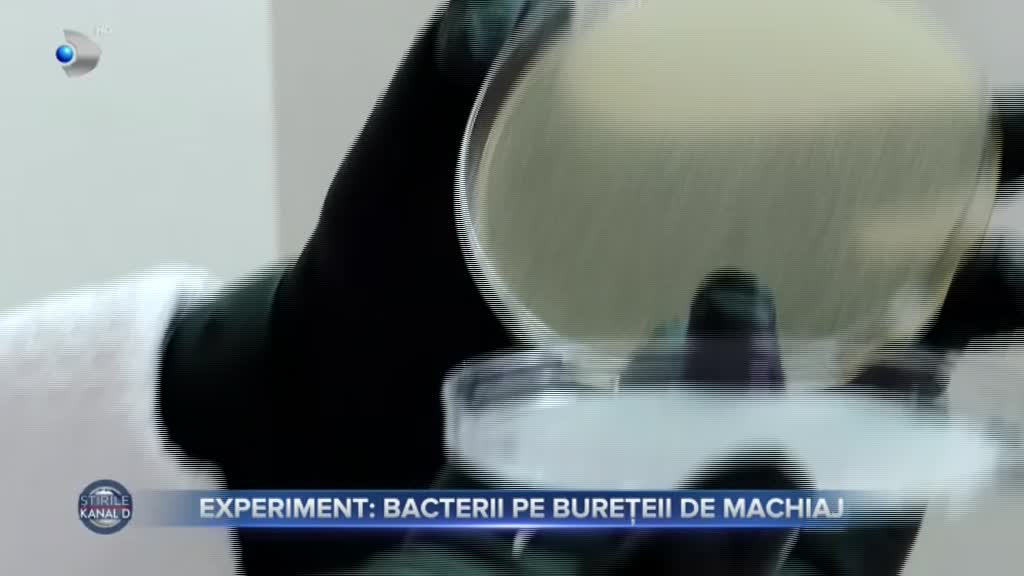

Cât de repede se murdăresc burețeii de machiaj, dar și cum trebuie folosite produsele de make-up, afli chiar acum!
Cât de des vă spălați burețeii și pensulele de machiaj? După fiecare utilizare, ne-ar îndemna medicii dermatologi. Însă de cele mai multe ori nu facem asta, iar tenul nostru are de suferit. Colega mea, Larisa Rațiu, a dus aceste instrumente de machiaj la laborator ca să vadă cât de curate mai sunt după trei zile de stat în portfard. Ce a descoperit e de-a dreptul uimitor. Priviți!, a
Experiment, bacterii pe burețeii de machiaj
Am dus la laborator un burețel și o pensulă de machiaj. Ambele au fost dezinfectate înainte cu trei zile, apoi folosite în fiecare zi și depozitate în trusa de machiaj. Am vrut să vedem dacă, într-un timp așa de scurt, s-au transformat în culcușuri pentru bacterii.
Vom lua proba și vom preleva de pe ea cu tamponul de recoltare. Acum prelevăm pe acest tampon de vată murdară, care se vede clar pe această pensulă... încărcătură microbiană, a spus reprezentantul de la laborator.
Facem același lucru și cu burețelul. Probele se prelucrează apoi prin metodele specifice. Urmează apoi să așteptăm rezultatele.
Fiecare analiză a scos la iveală adevărate colonii de micro-organisme, unele mai înfricoșătoare decât altele.
Nu a lipsit nici mucegaiul, pentru că burețelul se folosește cel mai des umezit.
Dar cum putem să limităm riscurile mai ales la salon, unde instrumentele se refolosesc la mai multe persoane?Cel mai important este să nu aplice produsul direct din ambalaj. De exemplu, dacă avem un ruj lichid niciodată nu vom folosi periuța de la rujul lichid, ci vom folosi o pensulă de unică folosință. La fel vom face și dacă este vorba de mascara... nu folosim niciodată ambalajul și pensula ca atare pe mai multe cliente ci folosim de fiecare dată o pensulă de unică folosință. Niciodată nu vom aplica pudra direct din ambalaj, varianta corectă este să punem puțină în capac și apoi dezinfectăm capacul. Cu ajutorul unei spatule, luăm o cantitate mică de produs, îl aplicăm pe mână și apoi, cu orice pensulă, luăm produsul și îl aplicăm pe model, a
Bacterii periculoase se pot ascunde și pe vârful creionului de buze. E suficient însă ca acesta să fie ascuțit imediat înainte de a trasa conturul.
„Am 23 ani și sunt reporter la Știrile Kanal D de aproape 2 ani. Lucrez în presă de 3 ani. Sunt absolventă a Facultății de Jurnalism și Științele Comunicării, specializarea Jurnalism și studentă în momentul de față la programul de masterat Comunicare și Resurse Umane în cadrul Facultății de Jurnalism, Universitatea București. Mi-am dorit încă de la vârsta de 10 ani să devin reporter de televiziune, mi-a plăcut dintotdeauna să fiu la curent cu tot ce se întâmpla în jur și sunt bucuroasă că mi-am îndeplinit visul. Acum, îi ajut pe cei care ne urmăresc în fiecare dimineața să afle cele mai importante știri și să fie la curent cu tot ce este nou”.